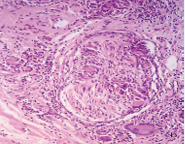
It is not easy to determine if this nerve is being infiltrated and destroyed by the cellular reaction or if it is simply surrounded by it.

Perineural and Intraneural Granulomas that are not Leprosy
- 1. Molecular Microbiology Group, School of Medicine, Universidad de La Sabana, USA
Abstract
Perineural and intraneural granulomatous inflammation is unique to leprosy. It is essential criteria for histopathological diagnosis in paucibacilary leprosy, with epithelioid or tuberculoid inflammation, in which bacilli are very difficult to demonstrate. A 27-year-old woman had erythematosus and hyper-pigmented plaques in the trunk, thigs, groins and legs, with 4 year evolution, without clear clinical diagnosis. Skin biopsy showed granulomatous dermal infiltrate, with giant cells with many nuclei and lymphocytes in their cytoplasm. Several giant cells surrounded, touched, or penetrated the cutaneous nerves, together with some macrophages. Few nerves had disintegrated perineurium and fragmented neural fibers. Granulomas rich in giant cells surrounded nerve fibers, which looked well preserved. The infiltrate showed also eosinophils. Giant cells surrounded small and medium sized vessels, whose elastic fibers were scarce, absent or phagocyted by the giant cells. Lymphocytes of the infiltrate had discrete atypia and epidermotropism. Perineural and intraneural granulomas suggested possibilities of tuberculoid leprosy, borderline tuberculoid leprosy or type 1 leprosy reaction. PAS, ZN, and Grocott stains did not show germs. The patient’s lesions were not hypo or anaesthetic. The described changes are typical of granulomatous mycosis fungoides. Our findings show that this cutaneous lymphoma can injure cutaneous nerves and simulate leprosy, but the magnitude of neural damage and the proper clinical pathological correlation make clear the difference between these two entities.
Keywords
Leprosy, Paucibacillary leprosy, Granulomatous mycosis fungoides, Histopathology
Citation
Rodriguez G (2016) Perineural and Intraneural Granulomas that are not Leprosy. J Dermatolog Clin Res 4(5): 1084.
ABBREVIATIONS
BTL: Borderline Tuberculoid Leprosy; GMF: Granulomatous Mycosis Fungoides; PAS: Periodic Acid Schiff; PB: Paucibacillary; R1: Type 1 Leprosy reaction; TL: Tuberculoid Leprosy; ZN: ZiehlNeelsen
INTRODUCTION
Histological diagnosis of Paucibacillary (PB) forms of leprosy with granulomas (Tuberculoid Leprosy (TL), Borderline Tuberculoid Leprosy (BLT) and Type 1 leprosy reaction (R1), is supported by showing neural changes produced by the disease that include perineural granulomas, perineural dissociation and penetration of the nerve by the granulomas, with its fragmentation and disintegration by the inflammatory infiltrate [1-3]. Only leprosy produces granulomatous perineural and intraneural inflammation, injuring and destroying the nerves. Perineural inflammation occurs with several infectious diseases, including the endoneural penetration of macrophages with Leishmania [4] or Histoplasma capsulatum [5], but without nerve bundle destruction as occurs in leprosy. The purpose of this work is to present a patient with cutaneous lesions whose skin biopsy showed perineural and intraneural granulomas, which suggested leprosy, but that corresponded to Granulomatous Mycosis Fungoides (GMF), a novel observation recently described [6].
CASE PRESENTATION
A 27 year old woman presented in the last four years erythematosus patches and plaques in the trunk, mammal region, thigs, groins and legs (Figure 1),

Figure 1 Erythematous, symmetric plaques of groins and thigs with morbiliform surface. Courtesy of Centro Dermatologico Federico Lleras. Bogotá.
that have increased in number and size. There are no important antecedents. Usual laboratory tests are normal. No clear clinical diagnosis was established.
Biopsy of the anterior thorax showed a dermal infiltrate rich in giant cells and lymphocytes that touched the epidermis and compromised all the dermis and the hypodermis (Figure 2).

Figure 2a Skin biopsy of the trunk. Panoramic view showing granulomatous infiltration of dermis and hypodermis with abundant giant cells and lymphocytes.

Figure 2b Sub epidermal granulomas rich in giant cells with lymphocytes, some of which penetrate the basal epidermis.

Figure 2c A giant cell of the infiltrate has numerous nuclei, is surrounded by mononuclear cells and has several lymphocytes in its cytoplasm (emperipolesis). A-C: HE. A, 2.5X B, 10 X. C, 40X..
The infiltrates surrounded several neural bundles, which had dissociated perineurium (Figure 3,4).

Figure 3a A nerve in the center of the figure has dispersed perineurium and is surrounded by a giant cell. The peripheral infiltrate has many giant cells with numerous nuclei, lymphocytes and eosinophils.

Figure 3b These nerves (lower right B) have no defined perineurium and are surrounded by diffuse infiltrate of macrophages, giant cells, lymphocytes and eosinophils.

Figure 3c These nerves have no defined perineurium and are surrounded by diffuse infiltrate of macrophages, giant cells, lymphocytes and eosinophils. Vacuolated macrophages seem to be endoneural.

Figure 3d This nerve does not show perineurium and is surrounded by prominent giant cells, but looks well preserved. A-D: HE. A, B: 16 X. C, D: 40 X.

Figure 4a This nerve is surrounded by granulomas and lymphocytes but its structure looks normal.
Figure 4b It is not easy to determine if this nerve is being infiltrated and destroyed by the cellular reaction or if it is simply surrounded by it.

Figure 4c Well preserved nerve with a giant cell, scant macrophages and some lymphocytes in the endoneurium. A-C: HE. A,10 X. B, 16 X. C, 40 X.
Some giant cells and macrophages touched the nerve or penetrate the endoneurium and distorted neural architecture (Figures 3,4). Other cutaneous nerves were located at the center of the infiltrate and looked well preserved (Figure 5).

Figure 5 These nerve bundle, located at the center of the granulomatous infiltrate, looks quite normal. This image is improper of leprosy. HE, 20X.
The possibility of TL, BTL, or type 1 leprosy reaction R1, was strongly suspected. PAS, Ziehl-Neelsen (ZN) and Grocott stains didn’t show germs. Small and medium sized vessels were surrounded by giant cells and lymphocytes and elastic fibers stain showed their absence or diminution in the lesion or in the vessels or their phagocytosis by the giant cells (Figure 6).

Figure 6a Medium size vein surrounded by abundant giant cells and lymphocytes.

Figure 6b Elastic stain demonstrates giant cells phagocytosing elastic fibers. A: HE, 20X. B, 40 X.
DISCUSSION
As in histologic figures show, we highlight the following:
1. The infiltrate occupies the entire thickness of the biopsy, which reaches the hypodermis. It also touches the epidermis and some lymphocytes exhibit epidermotropism.
2. Giant cells are very abundant, have numerous nuclei, are surrounded by histiocytic cells, S100+ (observation not shown), which have the tendency to adhere to them, and contain lymphocytes that have phagocyted or that have penetrated its cytoplasm (emperipolesis).There are many eosinophils in the infiltrate.
3. Giant cells surround the vessels and phagocyte the elastic fibers, which are scarce or are absent in most of the biopsy.
4. There is also atypia of lymphocytes, which in several sites touch and infiltrate the epidermis.
5. Infiltration of the nerves by giant cells and macrophages is discreet and does not destroy the nerve bundles.
6. While it is true that nerves have an ill-defined perineurium, they don’t look thickened, fragmented or infiltrated by lymphocytes, as it is usual in cases of paucibacilary leprosy with epithelioid granulomatous inflammation [1-3].
7. Normal and intact nerves at the center of the inflammation exclude the possibility of leprosy, since in this disease they contain 1000 times more bacilli than the inflammatory infiltrate [2], and are the target of the inflammation, which penetrates the nerves to destroy these bacilli. Inflammatory cells destroy the nerve, which becomes difficult to identify in the sections, so that immunohisto chemistry for S100 protein is very useful to identify remnant fibers [3]. This is particularly true in paucibacilary granulomatous, epithelioid forms of leprosy, such as LT, LBT and R1 [1-4]. In summary, well-preserved nerves at the center of epithelioid granulomas exclude the possibility of leprosy [3].
The four first mentioned criteria indicate that the patient has GMF, an entity with a difficult histological diagnosis, which causes it to be confused with granulomatous entities, mainly with sarcoidosis, and whose diagnostic confirmation will take years [7-11].
Clinical-pathological correlation in the demonstrated case verified that the lesions were not hypo or anaesthetic, as they should be if the patient had leprosy. TL courses with few erythematous, non-descamative, anesthetic, sharply defined plaques and neural thickening. DTL has many erythematous well defined, hairless plaques, hypo or anesthetic [1-3], while GMF does not have a special clinical presentation [8]. Lesions are papules, patches, erythematous plaques or nodules, usually umerous, asymptomatic or pruriginous and descamative [8]. Granuloma annular-like lesions may occur in leprosy and GMF but they are anesthetic in TL [1-3,8]. Hairless and anhidrotic lesions are present in leprosy and not in GMF. Granulomatous slack skin has a similar histological appearance to GMF but clinically presents bulky skin folds in axilla and groins [7-11].
Neural sensitivity in our patient was not specially explored, nor was it in other patients studied by us [6]. Clinical testing was limited to exploring sensitivity with cotton swabs, pins and hot and cold water, with no alterations detected. Nerve damage demonstrated in the biopsies is clear, but not as extensive and destructive as it is in leprosy, but better studies deserve to be realized in GMF.
We have verified endoneural granulomatous infiltration in several patients with GMF [6] an important fact for the pathologist, which not only can help not to confuse these findings with LT or LDT, but, indirectly, to evaluate the possibility of GMF, since only these entities generate endoneural granulomas.
REFERENCES
1. Scollard DM. The biology of nerve injury in leprosy. Lepr Rev. 2008; 7: 242-253.
3. Rodriguez G, Pinto R. Leprosy. Images and concepts. Medellin. Universidad de Antioquia and Universidad de La Sabana. 2007. (In Spanish)
4. Abbas O, Bhawan J. Cutaneous perineural inflammation: a review. J Cutan Pathol. 2010; 37: 1200 -1211.
11.Borroni R, Ackerman AB. Granulomatous mycosis fungoides including “granulomatous slack skin”. Ardor Scribendy. New York, 2008.








































































































































